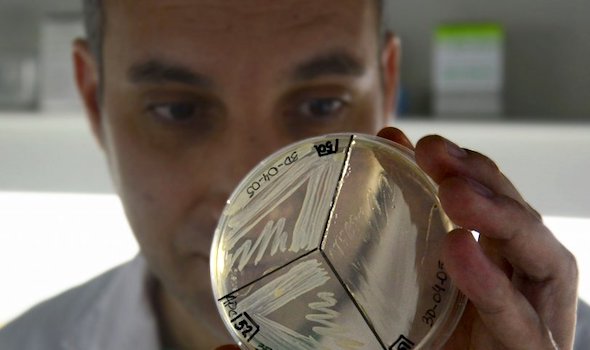

La empresa rosarina Sepal producirá un insumo clave para fabricar test de COVID para todo el país. La Pyme local fabricará un componente importado. La nueva tecnología estará disponible para mediados de 2022.
La firma desarrolló un prototipo de equipo purificador de agua ultrapura, destinada entre otras cosas a realizar los test de PCR en los estudios para coronavirus. Sepal es una empresa rosarina de 20 años dedicada a la fabricación y comercialización de unidades de tratamiento de agua para uso doméstico, industrial y microbiológico.
Este producto es altamente utilizado por laboratorios, institutos de investigación, hospitales y sanatorios, ya que resulta clave en la biología molecular y en la industria bioquímica. Actualmente, su mayor uso está en los test PCR para detección de coronavirus. Hoy esos equipos llegan al país provenientes de Estados Unidos, España y Alemania y ahora serán de fabricación nacional.
A partir de una asistencia económica del programa provincial Innovar Santa Fe 2020, comenzaron a desarrollar un prototipo que cuenta con varias innovaciones, como una doble ósmosis, tecnología de electrodesionización y un sistema de control a distancia con dispositivos de IOT.
El desarrollo, que llevan adelante en conjunto con expertos del INTI, permite que el cliente se despreocupe por entero del equipo, y le otorga un considerable ahorro. La nueva tecnología estará disponible para mediados de 2022.